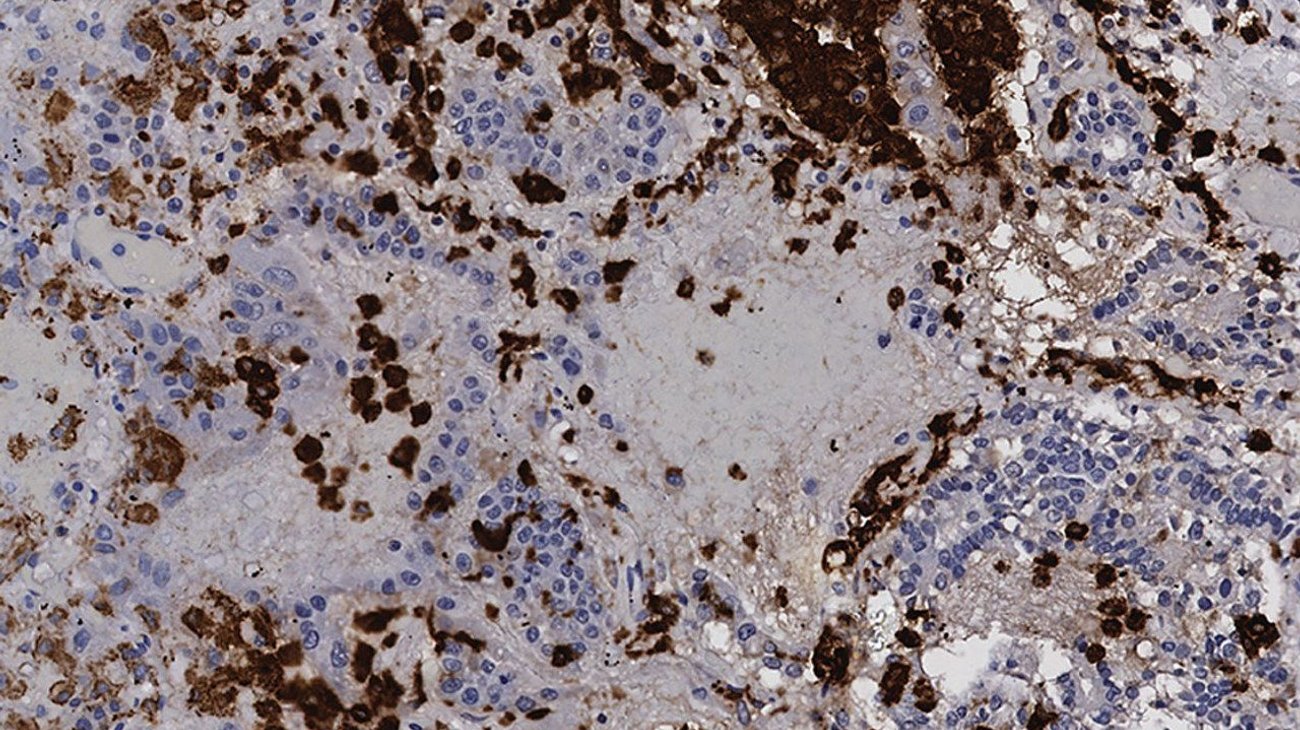
Investigan medicamento contra el cáncer para tratar covid-19

Un estudio liderado por la Universidad de California en San Diego propone usar un medicamento experimental contra el cáncer para tratar la COVID-19.
Hace doce años, investigadores identificaron una molécula que ayuda a las células cancerosas a sobrevivir al transportar células inflamatorias al tejido tumoral.
En esta nueva investigación, descubrieron que la misma molécula actúa de manera similar en el tejido pulmonar infectado por COVID-19 y que puede suprimirse con un fármaco contra el cáncer redirigido.
Publicado en Science Translational Medicine, el estudio propone un nuevo enfoque para prevenir daños irreversibles en órganos debido a enfermedades como la COVID-19 y el SARM (Staphylococcus aureus resistente a la meticilina).
Los actores clave son las células mieloides y la enzima PI3K gamma.
Las células mieloides del sistema inmunitario innato eliminan rápidamente patógenos como el SARS-CoV-2, pero pueden causar daños si se produce una sobreproducción de señales inflamatorias.
El estudio muestra que fármacos que impiden el reclutamiento de células mieloides dañinas pueden preservar la función tisular si se administran temprano en la infección.
La enzima PI3K gamma también ayuda a mover células mieloides a tejidos infectados.
Un fármaco contra el cáncer, eganelisib, podría suprimir la inflamación en COVID-19 al inhibir esta enzima.
Los investigadores encontraron resultados prometedores en tejido pulmonar humano y en ratones infectados con SARM.